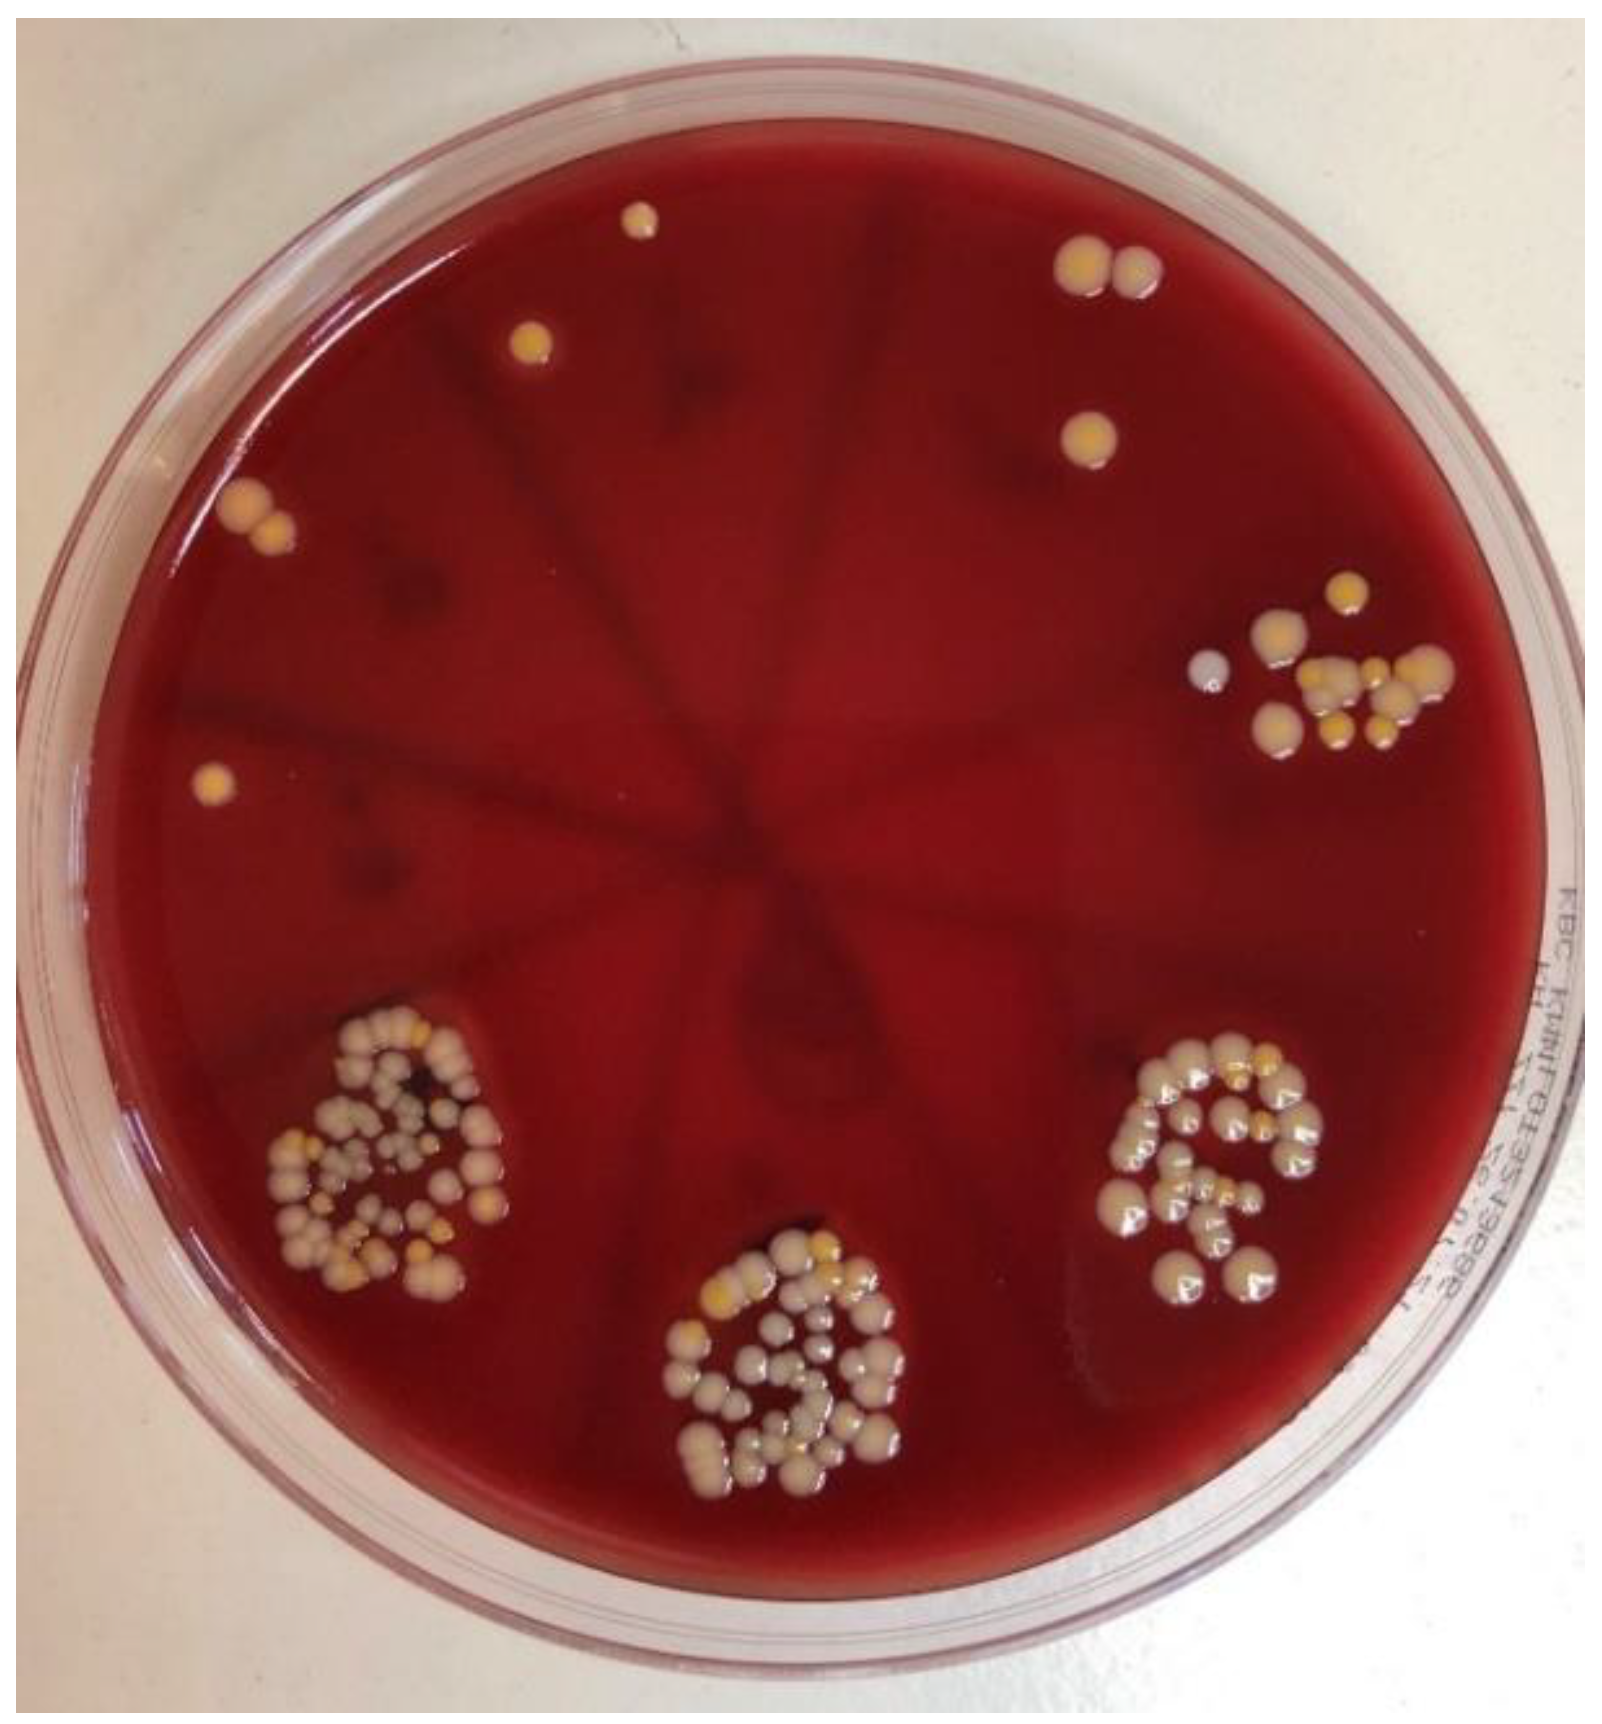
Ijms 23 08031 g011

Antimicrobial Efficacy and Permeability of Various Sealing Materials in Two Different Types of Implant–Abutment Connections
Abstract
:1. Introduction
2. Results
3. Discussion
4. Materials and Methods
4.1. Study Design
- GapSeal gel (Hager and Werken, Duisburg, Germany);
- Oxysafe gel (Hager and Werken, Duisburg, Germany);
- Flow.sil (Bredent GmbH and Co.KG, Senden, Germany).
4.2. Implant–Abutment Assembly Preparation
4.3. Contamination Procedure
4.4. Statistical Analysis
5. Conclusions
Author Contributions
Funding
Institutional Review Board Statement
Informed Consent Statement
Data Availability Statement
Conflicts of Interest
References
- Smojver, I.; Vuletić, M.; Sušić, M.; Marković, L.; Pelivan, I.; Gabrić, D. The Role of Candida Species in Peri-Implant Diseases. Australas. Med. J. 2020, 13, 98–105. [Google Scholar] [CrossRef]
- Mishra, S.K. Microleakage at the Different Implant Abutment Interface: A Systematic Review. J. Clin. Diagn. Res. 2017, 11, ZE10–ZE15. [Google Scholar] [CrossRef] [PubMed]
- Koutouzis, T. Implant-abutment Connection as Contributing Factor to Peri-implant Diseases. Periodontol. 2000 2019, 81, 152–166. [Google Scholar] [CrossRef]
- Kofron, M.D.; Carstens, M.; Fu, C.; Wen, H.B. In Vitro Assessment of Connection Strength and Stability of Internal Implant-Abutment Connections. Clin. Biomech. 2019, 65, 92–99. [Google Scholar] [CrossRef] [Green Version]
- Rismanchian, M.; Hatami, M.; Badrian, H.; Khalighinejad, N.; Goroohi, H. Evaluation of Microgap Size and Microbial Leakage in the Connection Area of 4 Abutments With Straumann (ITI) Implant. J. Oral Implantol. 2012, 38, 677–685. [Google Scholar] [CrossRef] [PubMed]
- D’Ercole, S.; D’Addazio, G.; Di Lodovico, S.; Traini, T.; Di Giulio, M.; Sinjari, B. Porphyromonas Gingivalis Load Is Balanced by 0.20% Chlorhexidine Gel. A Randomized, Double-Blind, Controlled, Microbiological and Immunohistochemical Human Study. J. Clin. Med. 2020, 9, 284. [Google Scholar] [CrossRef] [PubMed] [Green Version]
- Tallarico, M.; Fiorellini, J.; Nakajima, Y.; Omori, Y.; Takahisa, I.; Canullo, L. Mechanical Outcomes, Microleakage, and Marginal Accuracy at the Implant-Abutment Interface of Original versus Nonoriginal Implant Abutments: A Systematic Review of In Vitro Studies. Biomed Res. Int. 2018, 2018, 1–8. [Google Scholar] [CrossRef] [Green Version]
- Yao, K.; Kao, H.; Cheng, C.; Fang, H.; Huang, C.; Hsu, M. Mechanical Performance of Conical Implant-Abutment Connections under Different Cyclic Loading Conditions. J. Mech. Behav. Biomed. Mater. 2019, 90, 426–432. [Google Scholar] [CrossRef]
- Smojver, I.; Vuletić, M.; Gerbl, D.; Budimir, A.; Sušić, M.; Gabrić, D. Evaluation of Antimicrobial Efficacy and Permeability of Various Sealing Materials at the Implant–Abutment Interface—A Pilot In Vitro Study. Materials 2021, 14, 385. [Google Scholar] [CrossRef]
- Nagoor Meeran, M.F.; Javed, H.; Al Taee, H.; Azimullah, S.; Ojha, S.K. Pharmacological Properties and Molecular Mechanisms of Thymol: Prospects for Its Therapeutic Potential and Pharmaceutical Development. Front. Pharm. 2017, 8, 380. [Google Scholar] [CrossRef] [Green Version]
- de Buyl, F. Silicone Sealants and Structural Adhesives. Int. J. Adh. Adh. 2001, 21, 411–422. [Google Scholar] [CrossRef]
- Hager&Werken. Available online: https://www.hagerwerken.de/wp-content/uploads/2021/02/OXYSAFE-Gel-GA-0420-Homepage-kl.pdf (accessed on 12 May 2022).
- Schwarz, F.; Derks, J.; Monje, A.; Wang, H.-L. Peri-Implantitis. J. Periodontol. 2018, 89, S267–S290. [Google Scholar] [CrossRef] [PubMed]
- Belibasakis, G.N.; Charalampakis, G.; Bostanci, N.; Stadlinger, B. Peri-Implant Infections of Oral Biofilm Etiology. Adv. Exp. Med. Biol. 2015, 830, 69–84. [Google Scholar] [PubMed]
- Dabdoub, S.M.; Tsigarida, A.A.; Kumar, P.S. Patient-Specific Analysis of Periodontal and Peri-Implant Microbiomes. J. Dent. Res. 2013, 92, 168S–175S. [Google Scholar] [CrossRef] [PubMed] [Green Version]
- Sahrmann, P.; Gilli, F.; Wiedemeier, D.B.; Attin, T.; Schmidlin, P.R.; Karygianni, L. The Microbiome of Peri-Implantitis: A Systematic Review and Meta-Analysis. Microorganisms 2020, 8, 661. [Google Scholar] [CrossRef]
- Persson, G.R.; Renvert, S. Cluster of Bacteria Associated with Peri-Implantitis. Clin. Implant Dent. Relat. Res. 2014, 16, 783–793. [Google Scholar] [CrossRef]
- Negrini, T.D.C.; Koo, H.; Arthur, R.A. Candida–Bacterial Biofilms and Host–Microbe Interactions in Oral Diseases. Oral Mucosal Immun. Microbiome 2019, 1197, 119–141. [Google Scholar]
- Harris, L.G.; Mead, L.; Müller-Oberländer, E.; Richards, R.G. Bacteria and Cell Cytocompatibility Studies on Coated Medical Grade Titanium Surfaces. J. Biomed. Mater. Res. Part A 2006, 78A, 50–58. [Google Scholar] [CrossRef]
- Tsuruta, K.; Ayukawa, Y.; Matsuzaki, T.; Kihara, M.; Koyano, K. The Influence of Implant–Abutment Connection on the Screw Loosening and Microleakage. Int. J. Implant Dent. 2018, 4, 11. [Google Scholar] [CrossRef]
- Gherlone, E.F.; Capparé, P.; Pasciuta, R.; Grusovin, M.G.; Mancini, N.; Burioni, R. Evaluation of Resistance against Bacterial Microleakage of a New Conical Implant-Abutment Connection versus Conventional Connections: An in Vitro Study. New Microbiol. 2016, 39, 49–56. [Google Scholar]
- Discepoli, N.; Ferrari Cagidiaco, E.; Landini, G.; Pallecchi, L.; Garcia-Godoy, F.; Ferrari, M. Sealing Effectiveness against Staphylococcus Aureus of Five Different Implant-Abutment Connections. Am. J. Dent. 2018, 31, 141–143. [Google Scholar] [PubMed]
- Bittencourt, A.B.B.C.; Neto, C.L.d.M.M.; Penitente, P.A.; Pellizzer, E.P.; dos Santos, D.M.; Goiato, M.C. Comparison of the Morse Cone Connection with the Internal Hexagon and External Hexagon Connections Based on Microleakage—Review. Prague Med. Rep. 2021, 122, 181–190. [Google Scholar] [CrossRef] [PubMed]
- Lauritano, D.; Moreo, G.; Lucchese, A.; Viganoni, C.; Limongelli, L.; Carinci, F. The Impact of Implant–Abutment Connection on Clinical Outcomes and Microbial Colonization: A Narrative Review. Materials 2020, 13, 1131. [Google Scholar] [CrossRef] [PubMed] [Green Version]
- Ardakani, M.R.T.; Meimandi, M.; Amid, R.; Pourahmadie, A.D.; Shidfar, S. In Vitro Comparison of Microbial Leakage of the Implant-Healing Abutment Interface in Four Connection Systems. J. Oral Implantol. 2019, 45, 350–355. [Google Scholar] [CrossRef]
- Larrucea, C.; Conrado, A.; Olivares, D.; Padilla, C.; Barrera, A.; Lobos, O. Bacterial Microleakage at the Abutment-Implant Interface, In Vitro Study. Clin. Implant Dent. Relat. Res. 2018, 20, 360–367. [Google Scholar] [CrossRef]
- Candotto, V.; Gabrione, F.; Oberti, L.; Lento, D.; Severino, M. The Role of Implant-Abutment Connection in Preventing Bacterial Leakage: A Review. J. Biol. Regul. Homeost. Agents 2019, 33, 129–134. [Google Scholar]
- Yu, P.; Li, Z.; Tan, X.; Yu, H. Effect of Sealing Gel on the Microleakage Resistance and Mechanical Behavior during Dynamic Loading of 3 Implant Systems. J. Prosthet. Dent. 2022, 127, 308–317. [Google Scholar] [CrossRef]
- Seloto, C.; Strazzi-Sahyon, H.; dos Santos, P.; Assunção, W. Effectiveness of Sealing Gel on Vertical Misfit at the Implant-Abutment Interface and Preload Maintenance of Screw-Retained Implant-Supported Prostheses. Int. J. Oral Maxillofac. Implant. 2020, 35, 479–484. [Google Scholar] [CrossRef]
- Nayak, A.G.; Fernandes, A.; Kulkarni, R.; Ajantha, G.S.; Lekha, K.; Nadiger, R. Efficacy of Antibacterial Sealing Gel and O-Ring to Prevent Microleakage at the Implant Abutment Interface: An In Vitro Study. J. Oral Implantol. 2014, 40, 11–14. [Google Scholar] [CrossRef]
- Mohammadi, F.; Hajmousaei, M.; Vaziri, N.; Arshad, M. Bacterial Leakage at Implant-Abutment Interface with Different Intermediate Materials. J. Oral Implantol. 2019, 45, 451–455. [Google Scholar] [CrossRef]
- Smojver, I.; Bjelica, R.; Ćatić, A.; Budimir, A.; Vuletić, M.; Gabrić, D. Sealing Efficacy of the Original and Third-Party Custom-Made Abutments—Microbiological In Vitro Pilot Study. Materials 2022, 15, 1597. [Google Scholar] [CrossRef] [PubMed]
- Fiorillo, L. Chlorhexidine Gel Use in the Oral District: A Systematic Review. Gels 2019, 5, 31. [Google Scholar] [CrossRef] [PubMed] [Green Version]

| Flow.sil | OXYSAFE | GapSeal | Positive Control (CHX) | Negative Control | |
|---|---|---|---|---|---|
| S.aureus | 80.00% | 80.00% | 50.00% | 70.00% | 80.00% |
| C. albicans | 70.00% | 60.00% | 20.00% | 50.00% | 60.00% |
| Flow.sil | OXYSAFE | GapSeal | Positive Control (CHX) | Negative Control | |
|---|---|---|---|---|---|
| S.aureus | 90.00% | 90.00% | 60.00% | 80.00% | 90.00% |
| C. albicans | 70.00% | 60.00% | 20.00% | 50.00% | 60.00% |
| Connection Type | Subgroup | Fisher Exact Test (p Values) | ||
|---|---|---|---|---|
| Flow.sil | Oxysafe | GapSeal | ||
| straight and conical | positive (CHX) | H0 not rejected (0.465) | H0 not rejected (0.465) | H0 not rejected (0.320) |
| negative (no seal) | H0 not rejected (0.356) | H0 not rejected (0.605) | H0 rejected (0.008) * | |
| straight | positive (CHX) | H0 not rejected (1.000) | H0 not rejected (1.000) | H0 not rejected (0.650) |
| negative (no seal) | H0 not rejected (1.000) | H0 not rejected (1.000) | H0 not rejected (0.350) | |
| conical | positive (CHX) | H0 not rejected (0.605) | H0 not rejected (0.605) | H0 not rejected (0.628) |
| negative (no seal) | H0 not rejected (1.000) | H0 not rejected (1.000) | H0 not rejected (0.303) | |
| Connection Type | Subgroup | Fisher Exact Test (p Values) | ||
|---|---|---|---|---|
| Flow.sil | Oxysafe | GapSeal | ||
| straight and conical | positive (CHX) | H0 not rejected (0.333) | H0 not rejected (0.751) | H0 not rejected (0.096) |
| negative (no seal) | H0 not rejected (0.235) | H0 not rejected (0.065) | H0 rejected (0.000) * | |
| straight | positive (CHX) | H0 not rejected (0.650) | H0 not rejected (1.000) | H0 not rejected (0.350) |
| negative (no seal) | H0 not rejected (1.000) | H0 not rejected (1.000) | H0 not rejected (0.170) | |
| conical | positive (CHX) | H0 not rejected (0.650) | H0 not rejected (1.000) | H0 not rejected (0.350) |
| negative (no seal) | H0 not rejected (1.000) | H0 not rejected (1.000) | H0 not rejected (0.170) | |
Publisher’s Note: MDPI stays neutral with regard to jurisdictional claims in published maps and institutional affiliations. |
© 2022 by the authors. Licensee MDPI, Basel, Switzerland. This article is an open access article distributed under the terms and conditions of the Creative Commons Attribution (CC BY) license (https://creativecommons.org/licenses/by/4.0/).
Share and Cite
Smojver, I.; Bjelica, R.; Vuletić, M.; Gerbl, D.; Budimir, A.; Gabrić, D. Antimicrobial Efficacy and Permeability of Various Sealing Materials in Two Different Types of Implant–Abutment Connections. Int. J. Mol. Sci. 2022, 23, 8031. https://doi.org/10.3390/ijms23148031
Smojver I, Bjelica R, Vuletić M, Gerbl D, Budimir A, Gabrić D. Antimicrobial Efficacy and Permeability of Various Sealing Materials in Two Different Types of Implant–Abutment Connections. International Journal of Molecular Sciences. 2022; 23(14):8031. https://doi.org/10.3390/ijms23148031
Chicago/Turabian StyleSmojver, Igor, Roko Bjelica, Marko Vuletić, Dražena Gerbl, Ana Budimir, and Dragana Gabrić. 2022. "Antimicrobial Efficacy and Permeability of Various Sealing Materials in Two Different Types of Implant–Abutment Connections" International Journal of Molecular Sciences 23, no. 14: 8031. https://doi.org/10.3390/ijms23148031
APA StyleSmojver, I., Bjelica, R., Vuletić, M., Gerbl, D., Budimir, A., & Gabrić, D. (2022). Antimicrobial Efficacy and Permeability of Various Sealing Materials in Two Different Types of Implant–Abutment Connections. International Journal of Molecular Sciences, 23(14), 8031. https://doi.org/10.3390/ijms23148031

